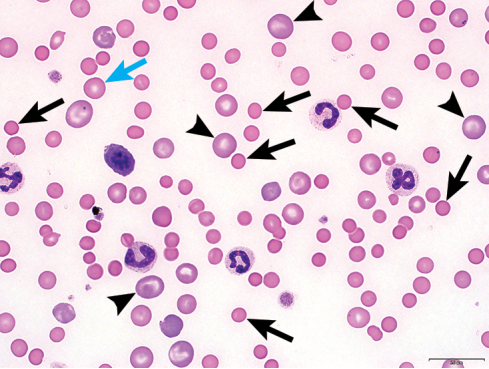

血涂片评估是血常规检查的重要部分,因为它可以提供关于动物和研究疾病的有价值的诊断和预后信息。理想情况下,每次血常规都应该做血涂片检查。 定期做血涂片可以使医生获得大量经验:包括更好地了解动物之间的正常差异;增强血涂片分析能力,从而减少因常见污染和样本收集、制备和储存而导致的人工误差带来的过度解释现象;提高识别异常形态的能力;提高判断异常现象是否有临床意义的能力。 即使血常规所有指标都在参考区间内,也可以在血涂片上发现异常。本文以下内容中的图片及分析主要关注红细胞形态。
A有明显再生迹象的犬免疫介导性溶血性贫血。 球状红细胞(黑色带柄箭头)体积更小,颜色偏暗的粉红色;与正常红细胞相比,它们没有中央苍白区(蓝色箭头)。频繁出现的大型多染性红细胞(短箭头)表明有再生,类似于网织红细胞。 
B犬正常血涂片 单层的正常红细胞(蓝色箭头)小于中性粒细胞并且中央苍白区较小。同时可观察到血小板(黑色箭头)和分叶中性粒细胞(短箭头)。 
C猫正常血涂片 与狗相比,正常的猫红细胞(蓝色箭头)几乎没有中央苍白区域。还可以看到血小板(黑色箭头),具有染色质小体(Howell-jolly body)的红细胞(粉红色箭头),淋巴细胞(箭头)。 
D支原体感染引起的幼猫的明显再生性贫血 这只幼猫的血细胞比容为4%,血涂片也可以看出红细胞不足。红细胞中可以看到小号球菌(蓝色箭头),在颜色较浅的血影细胞(即由于血管内溶血而失去内容物的红细胞,仅留下细胞膜和附着的微生物;红色箭头)。通常情况,支原体感染的病例主要是血管外溶血;然而,根据作者的经验,在严重病例中,如果有免疫球蛋白包裹的红细胞可以激活免疫系统的重要组成部分——补体系统,可能会出现不同程度的血管内溶血(上面图片中血影细胞的存在证明了这一点)。补体系统的主要功能是辅助快速和直接的摧毁靶细胞或病原体。频繁出现的大号多染性红细胞(短箭头)是再生的证据。图中还可以观察到血小板(黑色箭头)、2个中性粒细胞,淋巴细胞(顶部中间)。治疗方法为输血和强力霉素,最终已康复。 
E血管内皮瘤引起的犬再生性贫血伴有棘形红细胞和裂红细胞 当同时观察到裂红细胞(红色箭头),棘形红细胞(蓝色箭头)和大的多染性红细胞(短箭头)时应想到血管瘤。棘形红细胞可能很难与棘形细胞(即皱缩红细胞)区分。棘形红细胞具有更明显更宽的钝性凸起,看上去像船桨或在末端有额外的延伸。还可以观察到血小板(黑色箭头)。 |